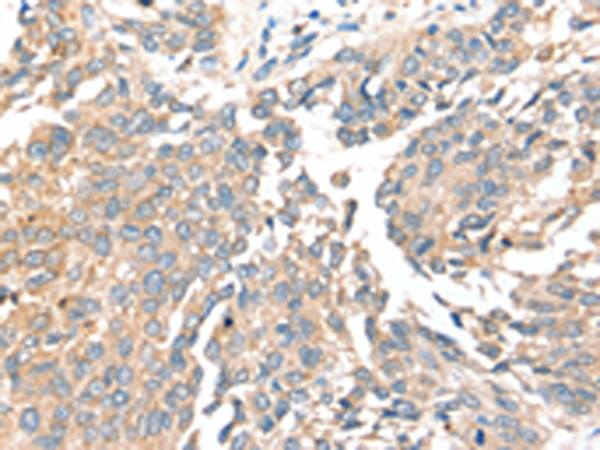
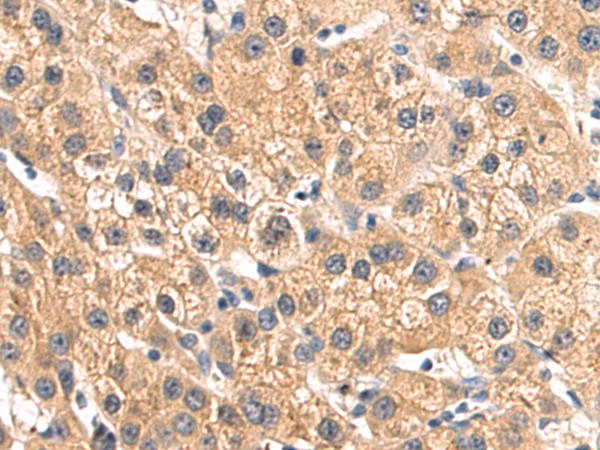

-
分类: 科研抗体货号: P12174别名: SIR2L4应用: IHC反应种属: Human, Mouse
-
分类: 科研抗体货号: P12200别名: HND; B0AT1应用: IHC反应种属: Human
-
分类: 科研抗体货号: P12173别名:应用: IHC反应种属: Human, Mouse
-
分类: 科研抗体货号: P12199别名: CRT; CT1; CRTR; CTR5; CCDS1应用: IHC反应种属: Human, Mouse, Rat
-
分类: 科研抗体货号: P12172别名: CD33L3; HsT1361; SIGLEC-15应用: IHC反应种属: Human
-
分类: 科研抗体货号: P12198别名: BCW2; SMIT; SMIT1; SMIT2应用: IHC反应种属: Human, Mouse
-
分类: 科研抗体货号: P12171别名:应用: IHC反应种属: Human
-
分类: 科研抗体货号: P12197别名: KST1; RKST1; SGLT6; SMIT2应用: IHC反应种属: Human, Mouse, Rat
-
分类: 科研抗体货号: P12170别名:应用: IHC反应种属: Human
-
分类: 科研抗体货号: P12195别名: CTL2; PP1292应用: IHC反应种属: Human

鄂公网安备42018502007531号
鄂公网安备42018502007531号

